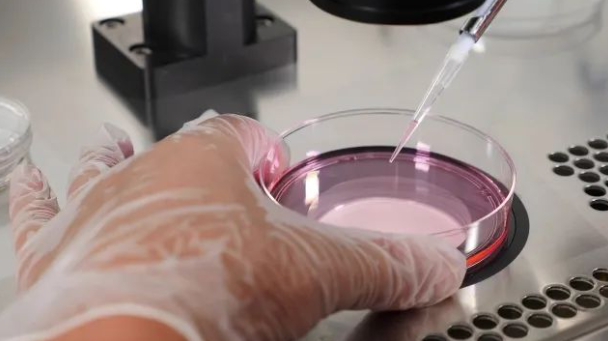
试验.png

当女性有HIV阳性的时候,如何生育健康的宝宝呢?在过去,在有效的HIV药物之前,每四个HIV阳性妇女中就有一个将其感染传染给她们的婴儿。今天,在怀孕前和怀孕期间服用非常有效的HIV药物后,婴儿感染HIV的风险低于2%。如果母亲的病毒载量非常低,并且没有其他医疗原因需要剖腹产,那么HIV阳性的妇女可以通过阴道分娩。不过目前没有一个具体的数值可以保证,新生儿的百分百不感染。当然也有很多人会考虑海外代孕的方式,但是如果女方有HIV感染,大部分诊所是不接受该女性取卵的,就算有诊所愿意操作试管取卵手术,也没有代母愿意接受移植可能感染HIV的胚胎。 婴儿出生后,HIV阳性的妇女必须避免母乳喂养,因为母亲可以通过母乳喂养将HIV传染给婴儿。
那如果男方为HIV感染者,能否生育出健康的宝宝呢?其实是可以实现的,这比女方感染HIV更加简单和安全。首先,在备孕前,HIV感染者一定要尽早服用抗病毒药物,坚持规范的抗病毒治疗,保证体内的病毒载量长期(6个月以上)检测不到,这时基本没有病毒传染性,才可以通过自然孕育或借助试管婴儿手术,安全完成受精的过程。 如果选择自然受孕的方式,HIV阴性的一方,在无套性交前、后的一个月要分别服用暴露前预防药物(PrEP)和暴露后预防药物(PEP),以预防HIV感染。同时,在高危性行为后要进行HIV抗体检测,排除HIV的性传播,这种传统的方式还是有较大的风险的。 目前更安全的方式是通过试管婴儿来完成健康生育。当男方携带有HIV,在试管婴儿过程中就需要运用洗涤精子技术(全名离心精浆分离技术)和第三代试管婴儿基因筛查技术。所以,“洗精”实际上是分离出精子和其他物质如精液、白血球细胞等,再进一步筛选出可用于辅助生殖技术的精子(高比例、形态正常、活动力强的),检测合格后才和卵子体外结合,最后将健康的胚胎移植到母体宫腔中着床妊娠,进行生长发育,保证母体和胚胎都健康安全。这种方法可以去除有问题的精子,提取到健康的精子;然后利用试管婴儿技术,把健康精子和卵子体外结合形成受精卵;再通过PGD/PGS基因筛查技术,对受精卵培育成的囊胚进行检测。 不过可惜的是,中国国内大部分医院不建议HIV感染者做试管婴儿。所以HIV男性感染者可以去往美国或者泰国,通过先进的洗精手术,做试管婴儿和代孕生育健康后代。如果需要代孕的话只能去美国了,因为从2014年开始,泰国已经禁止代孕。 |